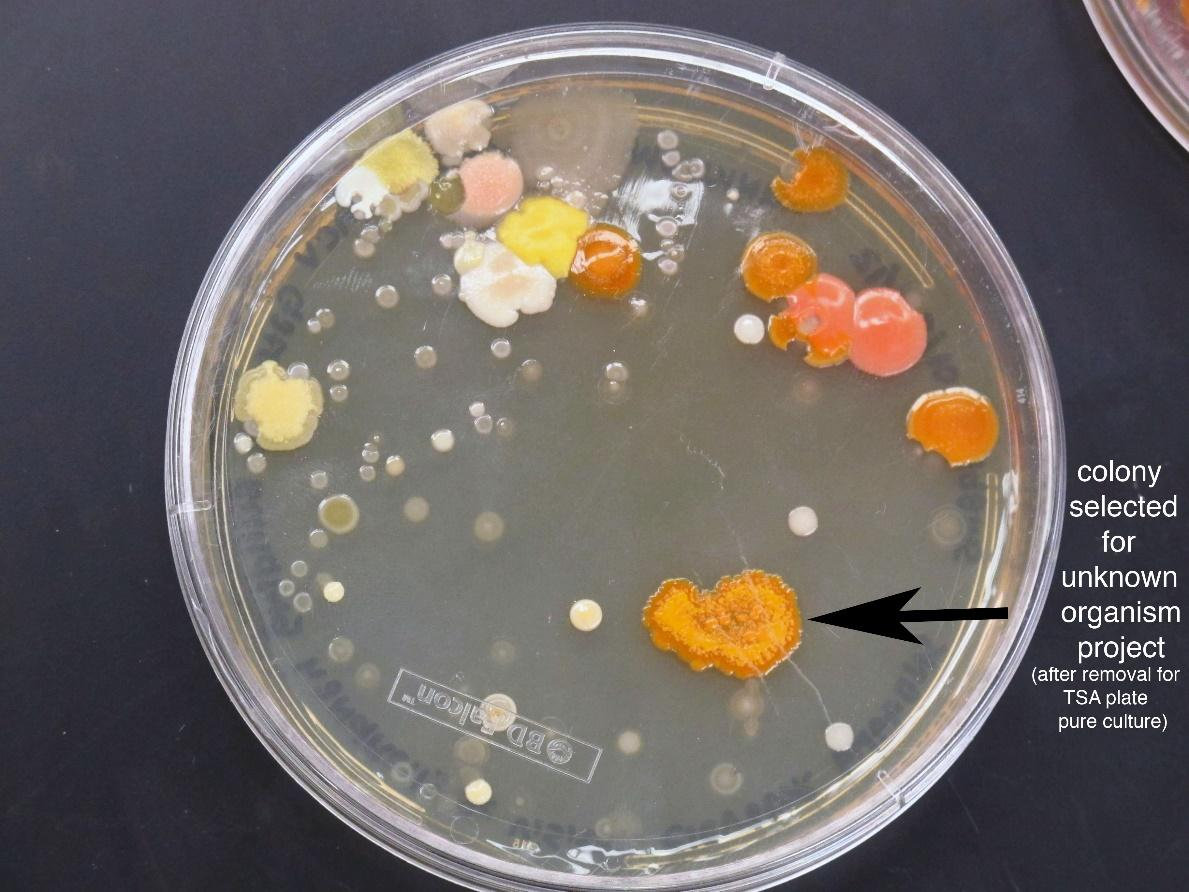
seo images

Axenic culture is
(A) Culture of tissue
(B) Culture of genes
(C) Pure culture without contamination
(D) Pure culture of microbes without any external nutrients.
Answer
605.7k+ views
Hint: Axenic is defined as the state of the culture in which the particular species or the variety or the strain of the particular organism is only present in the culture without the existence of any other microorganism. This type of culture is possible for both unicellular microorganisms and also multicellular organisms.
Complete Answer:
- This axenic culture is mainly followed for the microorganisms like bacteria and other unicellular eukaryotic organisms.
- In this culture, the organisms are taken and it is diluted to produce many subsamples. The dilution of the culture is made in such a way that the subsamples correctly contains only one organism in case of the asexual organisms or two organisms in case of sexual organisms.
- These subsamples are cultured to produce the pure axenic culture. The culture medium is checked periodically in order to find whether the culture is contaminated or in the axenic condition.

After that the culture is checked for its contamination. The sample is kept on the agar plate. Since the agar is the enriching medium for the growth of microorganisms, the contaminating organisms grow by getting the nutrients from it. If the culture is pure, no organisms grow from the agar plate.
Note: This culture is mainly used for the purpose of the study of the characteristics of the parasitic and the symbiotic organisms in the controlled culture condition. For example, this is used in the culture of entamoeba, fungi growth in the lichens etc.
Complete Answer:
- This axenic culture is mainly followed for the microorganisms like bacteria and other unicellular eukaryotic organisms.
- In this culture, the organisms are taken and it is diluted to produce many subsamples. The dilution of the culture is made in such a way that the subsamples correctly contains only one organism in case of the asexual organisms or two organisms in case of sexual organisms.
- These subsamples are cultured to produce the pure axenic culture. The culture medium is checked periodically in order to find whether the culture is contaminated or in the axenic condition.
After that the culture is checked for its contamination. The sample is kept on the agar plate. Since the agar is the enriching medium for the growth of microorganisms, the contaminating organisms grow by getting the nutrients from it. If the culture is pure, no organisms grow from the agar plate.
Note: This culture is mainly used for the purpose of the study of the characteristics of the parasitic and the symbiotic organisms in the controlled culture condition. For example, this is used in the culture of entamoeba, fungi growth in the lichens etc.
Recently Updated Pages
Master Class 12 Business Studies: Engaging Questions & Answers for Success

Master Class 12 Biology: Engaging Questions & Answers for Success

Master Class 12 Chemistry: Engaging Questions & Answers for Success

Class 12 Question and Answer - Your Ultimate Solutions Guide

Master Class 11 Social Science: Engaging Questions & Answers for Success

Master Class 11 English: Engaging Questions & Answers for Success

Trending doubts
Which are the Top 10 Largest Countries of the World?

Draw a labelled sketch of the human eye class 12 physics CBSE

Differentiate between homogeneous and heterogeneous class 12 chemistry CBSE

Sulphuric acid is known as the king of acids State class 12 chemistry CBSE

Why is the cell called the structural and functional class 12 biology CBSE

Which is the correct genotypic ratio of mendel dihybrid class 12 biology CBSE




